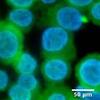
Research

Diffregen LLC, a Temple University startup company, has been awarded a small business innovation research (SBIR) Phase 1 grant by the National Cancer Institute to advance Angiocidin, a university-created therapeutic to treat acute myeloid leukemia (AML), to the doorstep of human clinical trials.
[node:pullquote]
Discovered by Temple researcher George Tuszynski, now emeritus professor of neuroscience in Temple’s School of Medicine, Angiocidin is a novel tumor-inhibiting protein that has shown effectiveness against AML in early pre-clinical testing.
AML is a fatal disease that halts the maturation of white blood cells, causes immune system suppression and leads to secondary problems such as infection and pneumonia. Angiocidin has demonstrated the ability to stimulate maturation in the affected white cells, causing them to behave and function like normal cells.
The one-year, $289,000 grant will allow Diffregen to begin manufacture of Angiocidin with a contract manufacturer, confirm key data in a third party lab and extend studies in standard animal models of AML, said Deni Zodda, Diffregen’s chief executive officer.
“At the end of this grant, we will have the beginning of a pre-clinical data set that will serve as the foundation for future submission of an investigational new drug (IND) application with the U.S. Food and Drug Administration,” said Zodda. “We will be asking the FDA’s permission to test this drug in humans.”
Based on the new data generated by the SBIR funding and the ability to attract additional funding, Zodda estimated that Diffregen will submit an IND application and start clinical trials in three to four years.
Since Temple filed a patent on Angiocidin in 2008, the university’s growing relationship with the University City Science Center has played a significant role in helping to advance the technology.
In 2011, Tuszynski was awarded a $100,000 proof-of-concept grant through the Science Center’s QED program — Temple’s first QED grant from the Science Center — to start moving the technology from the laboratory to the marketplace. The university matched that grant with $100,000 in funding from the Commonwealth of Pennsylvania.
The grant allowed Tuszynski to conduct early pre-clinical experiments which demonstrated the initial effectiveness of Angiocidin as a therapeutic against patient AML cells, both in vitro and in vivo, using a novel mouse model.
Once the QED funding was secured from the Science Center, Temple spun out Diffregen, with Zodda as the company’s CEO, said Stephen Nappi, director of technology development and commercialization in Temple’s Office of the Senior Vice Provost for Research.
“In this case, Temple’s relationship with the University City Science Center also led to the introduction to the startup’s CEO, Deni Zodda, which is usually a major challenge for us in the tech transfer office,” said Nappi. “Deni was the QED business advisor assigned to Temple’s QED proposal for Angiocidin.”
Zodda said the Science Center’s QED funding was critical to providing Tuszynski and Diffregen the ability to acquire early feasibility data that was reviewed by NCI in their decision to award Diffregen the SBIR funding to put Angiocidin on the path to human clinical trials.
Temple’s relationship with the Science Center also played a role in helping Diffregen meet one of the key requirements for SBIR funding — that the company have legitimate office and lab space. Temple leases such space at the Science Center’s Port Business Incubator, which they were able to provide to Diffregen.
“The Temple space at the University City Science Center is very important to giving the company an aura of legitimacy,” said Zodda. “And because Temple provides the space to the company at a very reasonable rate, it is a very cost-effective way to meet the federal requirements. Plus, it means more of our financial resources are going into the science and not to a landlord.”
“Diffregen demonstrates the impact that the Science Center and its QED proof-of-concept funding program can have on emerging technologies,” said Christopher J. Laing, vice president for science and technology at the University City Science Center. “In Diffregen’s case, it has enabled the creation of an exciting new start-up company, with an accomplished team, that has attracted funding from the National Cancer Institute. In the end it will be patients that benefit from new approaches to treating leukemia.”
Nappi said the awarding of the SBIR funding, which is a very rigorous examination of both the technology and company, is significant for Temple because it will make Angiocidin the university’s second most advanced therapy behind Rigosertib, a cancer therapy licensed by Onconova Therapeutics that is now in advanced clinical trials.
“This whole discovery and commercialization process for Angiocidin and Diffregen has been homegrown,” said Nappi. “Everything has been developed and advanced through key milestones because of programs put in place here at Temple or in partnership with the University City Science Center.”
“At the end of this grant, we will have the beginning of a pre-clinical data set that will serve as the foundation for future submission of an investigational new drug (IND) application with the U.S. Food and Drug Administration,”

